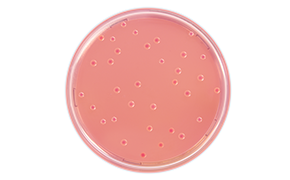
Bile Tolerant Gram Negative Bacteria
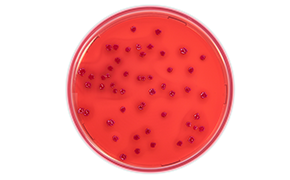
Escherichia Coli
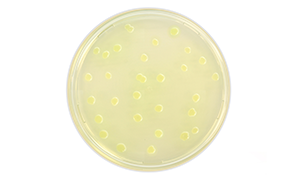
Pseudomonas Aeruginosa
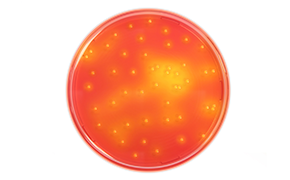
Staphylococcus Aureus
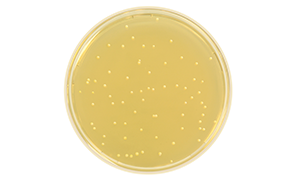
Candida Albicans

Culture Media for Microbial Limit Tests
Microbial limit tests are standardized methods for many pharmaceutical raw materials and finished products. Testing and compliance with these standards detailed within microbial limit tests is a basic requirement for the global product development, release, and distribution of pharmaceutical ingredients and drug products. Microbial limit tests are performed to determine drug compatibility, and safety or for routine quality control.
MICROBIOLOGICAL QUALITY CONTROL OF NON-STERILE PRODUCTS
The three internationally most important Pharmacopoeias (Ph Eur/JP/USP) published harmonized versions of their chapters on microbial examination of non-sterile products in 2009. In addition, the 2016 edition of the Chinese Pharmacopoeia is, for the most part, harmonized in terms of media composition and performance criteria, although growth promotion testing needs to be performed with strains from the Chinese strain collection. These methods address the total aerobic count (TAMC and TYMC) and the test for specified microorganisms.
Our culture media portfolio for microbial examination of non-sterile products complies with the harmonized Pharmacopoeia. As microbial limit tests change, be assured that we monitor this thoroughly, and any changes to composition or performance testing will be implemented quickly so that you won’t need to worry about the regulatory compliance of our media.

We provide a choice of products for all culture media and substances required for:
Browse from our range of products to support your microbial limit tests:
MICROBIOLOGICAL QUALITY CONTROL OF NON-STERILE PRODUCTS
The three internationally most important Pharmacopoeias (Ph Eur/JP/USP) published harmonized versions of their chapters on microbial examination of non-sterile products in 2009. In addition, the 2016 edition of the Chinese Pharmacopoeia is, for the most part, harmonized in terms of media composition and performance criteria, although growth promotion testing needs to be performed with strains from the Chinese strain collection. These methods address the total aerobic count (TAMC and TYMC) and the test for specified microorganisms.
Our culture media portfolio for microbial examination of non-sterile products complies with the harmonized Pharmacopoeia. As microbial limit tests change, be assured that we monitor this thoroughly, and any changes to composition or performance testing will be implemented quickly so that you won’t need to worry about the regulatory compliance of our media.
PHARMACOPEIA Microbial Limit Testing
Regulatory agencies must implement pharmaceutical drug testing and follow the respective pharmacopeia methods or validated methods.
European Directorate for the Quality of Medicines and Healthcare (2017)
The European Pharmacopoeia. 9th Ed. Chapter 2.6.12 Microbiological examination of non-sterile products: Microbial enumeration tests and Chapter 2.6.13 Microbiological examination of non-sterile products: Test for specified products. Strasbourg, France.
Japanese Ministry of Health, Labour and Welfare (2016)
The Japanese Pharmacopoeia. 17th Ed. Chapter 4.05 Microbial Limit Test I. Microbiological examination of non-sterile products: Total viable aerobic count and II. Microbiological examination of non-sterile products: Test for specified products. Japanese Ministry of Health, Labour, and Welfare. Tokyo, Japan.
United States Pharmacopeial Convention (2014)
The United States Pharmacopeia 38/National Formulation 33, Supp. 2. Chapter <61> Microbiological examination of non-sterile products: Microbial enumeration tests and Chapter <62> Microbiological examination of non-sterile products: Test for specified products. Rockville, Md., USA.
Microbial Limit Tests FOR MICROBIAL ENUMERATION
Microbial Enumeration Tests are quantitative methods to determine the contamination level of mesophilic bacteria and fungi that grow under aerobic conditions in a pharmaceutical product. The tests include detecting the total aerobic microbial count (TAMC) and total yeast and mold count (TYMC). Membrane Filtration, Plate-Count, or the Most-Probable-Number (MPN) is the most common enumeration method, and the choice of method depends on the test product.
Before a method is chosen, the suitability should be proven in the presence of the product. This involves the preparation of suitable test strains, growth promotion tests of the culture media, and suitability tests for the counting method in the presence of the product.

Figure 1.Diagram for microbial enumeration testing between 1. TAMC: Mixed microbial growth on Soybean Casein Digest Agar, and 2. TYMC: Mixed Yeast and Mold growth on Sabourated Dextrose Agar. A) Soybean Casein Digest Agar B) Soybean Casein Digest Broth C) Sabouraud Dextrose Agar D) Sabouraud Dextrose Agar with Chloramphenicol*
*Can be used to suppress bacterial growth threatening to exceed TYMC acceptance criteria.

- Bile-Tolerant Gram-Negative Bacteria
- Escherichia coli
- Salmonella
- Pseudomonas aeruginosa
- Staphylococcus aureus
- Clostridia
- Candida albicans
These organisms serve as general indicator organisms, but depending on the nature of the product, its designated use, the recipient group, and the method of application, other pathogenic microorganisms may be relevant. The following overview of required media is limited to explicit Pharmacopoeia requirements.
Bile-Tolerant Gram-Negative Bacteria
Dilution / Enrichment:
Soybean Casein Digest Broth
Enterobacteria Enrichment
Broth Mossel
Subcultivation:
Violet RedBile Glucose Agar
Escherichia coli
Dilution / Enrichment:
Soybean Casein Digest Broth
MacConkey Broth
Subcultivation:
MacConkey Agar

Salmonella
Dilution / Enrichment:
Soybean Casein Digest Broth
Rappaport-Vassiliadis
Salmonella Enrichment Broth
Subcultivation:
Xylose Lysine Deoxycholate Agar
Pseudomonas aeruginosa
Dilution / Enrichment:
Soybean Casein Digest Broth
Subcultivation:
Cetrimide Agar
Staphylococcus aureus
Dilution / Enrichment:
Soybean Casein Digest Broth
Subcultivation:
Mannitol Salt Agar
Candida albicans
Dilution / Enrichment:
Sabouraud Dextrose Broth
Subcultivation:
Sabouraud Dextrose Agar
Clostridia
Dilution / Enrichment:
Reinforced Medium for Clostridia
Subcultivation:
Columbia Agar
Dilution Media
Dehydrated Culture Media (DCM)
Culture media - Ready-to-use plate
Culture media - Ready-to-use liquid
Neutralizing agents
To continue reading please sign in or create an account.
Don't Have An Account?